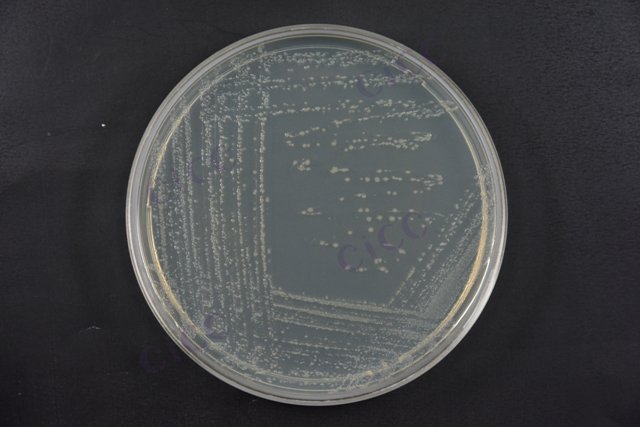
福氏志贺氏菌 Shigella flexneri CICC 10865 Shigella flexneri

福氏志贺氏菌 Shigella flexneri CICC 10865 Shigella flexneri
-
福氏志贺氏菌 Shigella flexneri CICC 21534 Shigella flexneri
CICC 21534 | 见证书
-
福氏志贺氏菌 Shigella flexneri
BNCC185915 | 冻干粉;斜面;菌液;平板
-
福氏志贺氏菌 Shigella flexneri
BNCC379706 | 冻干粉;菌液;平板
-
福氏志贺氏菌 Shigella flexneri
BNCC381391 | 冻干粉;斜面;菌液;平板
-
福氏志贺氏菌 Shigella flexneri
BNCC379708 | 冻干粉;菌液;平板
-
福氏志贺氏菌 Shigella flexneri
BNCC379707 | 冻干粉;菌液;平板
-
福氏志贺氏菌 Shigella flexneri
BNCC186339 | 冻干粉;斜面;菌液;平板

说明书下载: 菌种说明书 打管说明书
您正在浏览的产品:福氏志贺氏菌 Shigella flexneri CICC 10865
手机版:福氏志贺氏菌 Shigella flexneri CICC 10865
本公司销售的所有产品仅供实验科研使用,不用于人体及临床诊断。
1. 增菌肉汤(含新生霉素)在41.5±1℃厌氧培养16-20小时;
2. 使用XLD琼脂、MAC琼脂或志贺显色培养基分离培养[1]。
2. 样品处理需均质混匀,保证分散性[1][4]。
2. 增菌液划线接种至选择性平板,36±1℃培养20-24小时;
3. 菌落形态观察(XLD琼脂上呈无色透明或淡粉色菌落)[1][4]。
2. 厌氧培养条件可有效抑制非目标菌生长[1][4]。
以上信息仅供参考,请以相应标准的原文为准!